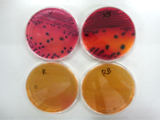
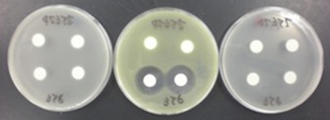

輸入食品の検査
検査の流れ
全国の検疫所の食品監視担当課でサンプリングされた試験品は、検査センターに搬送されてきます。受付けられた試験品は、検査項目により、それぞれの検査室に搬送されます。
- 食品監視担当課
※搬送- 検査センター受領
※受付:試験品番号の付与- 試験検査
※微生物学的試験検査、理化学的試験検査- 結果の確認

- 試験成績の発行
検査
1 微生物学的試験検査
我が国に輸入される食品の食中毒原因微生物を中心とした病原微生物検査、残留抗生物質等の検査を実施し、輸入食品の安全性を確保しています。
(1)病原微生物検査
畜水産食品、野菜・果実等について病原性の強い腸管出血性大腸菌、コレラ菌、ノロウイルス、A型肝炎ウイルス、Kudoa septempunctata、Sarcocystis fayeri等の検査を実施しています。
(2)残留抗生物質検査
各種抗生物質に感受性のある細菌を用いて、畜水産食品、はちみつ等の残留抗生物質の検査を実施しています。
(3)遺伝子組換え食品検査
穀類、パパイヤ及びそれらの加工品について日本で安全性が確認されていない遺伝子組換え品種が混入していないか、遺伝子検査を実施しています。
2 理化学的試験検査
我が国に輸入される食品の安全性を確保するために、GC/MS/MS等の高度な分析機器を用いて、さまざまな食品中等の添加物、残留農薬、残留動物用医薬品、有害有毒物質、おもちゃ・容器包装の規格等の検査を実施しています。
(1)添加物検査
各国の添加物の使用基準に基づき使用され輸入される可能性があります。
このため、加工食品中の酸化防止剤、甘味料、着色料等の添加物について検査を実施しています。
(2)残留農薬検査
野菜・果実、穀類、畜水産食品、加工食品等に使用されている農薬(有機リン系、ピレスロイド系農薬等)について検査を実施しています。
(3)動物用医薬品検査
畜水産食品、魚介類等に使用されている抗菌性物質 (マクロライド系抗生物質、サルファ剤等)、内寄生虫駆除剤、ホルモン剤等について検査を実施しています。
(4)有害有毒物質検査
穀類等のカビ毒(アフラトキシン等)、米、魚介類の重金属(水銀等)等について検査を実施しています。
また、食品中の放射性物質、放射線照射食品についても検査を実施しています。
(5)おもちゃ・容器包装等検査
乳幼児用おもちゃの着色料、重金属等について検査を実施しています。
また、飲食に用いる器具等(食器、包装)について、重金属の検査を実施しています。